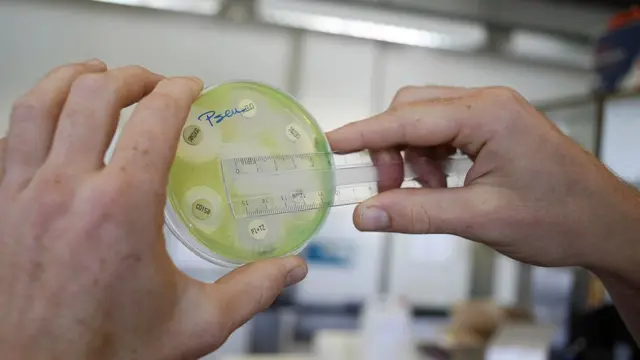
Bacterias

Por qué es tan difícil desarrollar nuevos antibióticos

Fuente de la imagen, Getty Images
- Autor, Tim Jinks*
- Título del autor, Wellcome Trust
La dependencia excesiva y el mal uso de los antibióticos han conducido a advertencias de un futuro sin estos medicamentos. Pero, ¿por qué ha sido tan difícil para los científicos descubrir una nueva generación de estas medicinas?
La historia de este descubrimiento científico es conocida en todo el mundo: el hallazgo fortuito de un hongo que revolucionó la medicina moderna.
Hace casi 90 años, Alexander Fleming regresó de sus vacaciones y encontró Penicillium en una placa de Petri en su laboratorio en el sótano del Hospital St Mary en Londres.
Para los 1950, la época de oro de los antibióticos, se había creado una serie de nuevas medicinas.
Hoy los científicos están buscando un nuevo logro, probando microbios en fuentes tan diversas como tierra, cuevas y sangre del dragón de Komodo, además de trabajar en el desarrollo de nuevas medicinas sintéticas en el laboratorio.

Fuente de la imagen, Getty Images
Pero a pesar de estos extraordinarios avances, nos estamos quedando sin antibióticos efectivos, sin los fármacos que combaten infecciones y son esenciales para todo, desde trasplantes de órganos hasta el tratamiento de la intoxicación alimentaria.
Las bacterias letales resistentes a la penicilina o a los más de 100 antibióticos diferentes que se han desarrollado, ya están matando a unas 700.000 personas cada año.
Si no se combate, la cifra global podría aumentar a 10 millones al año para 2050.
Si el problema es tan grave ¿por qué, en esta era de increíbles avances médicos y científicos, ha sido tan difícil obtener los nuevos antibióticos que el mundo necesita de forma tan urgente?
Contra los supermicrobios
La respuesta está en parte en el desafío científico y en parte en la crisis económica del trabajo de investigación y desarrollo.
Quizás la parte menos conocida de la historia de Fleming es el largo período de investigación y colaboración que realizó durante los 1940, antes de que el Penicillium se convirtiera en el primer antibiótico del mundo.

Fuente de la imagen, Getty Images
O que el propio Fleming advirtió desde el inicio que la bacteria podía volverse resistente a los medicamentos.
Como paciente, los antibióticos pueden parecer un simple tratamiento para infecciones, pero el fármaco tiene una compleja relación con la misma bacteria que fue diseñado para destruir.
Todos los microorganismos evolucionan. Los que desarrollan defensas contra los antibióticos sobrevivirán y quienes no tienen defensas morirán.
Entre más antibióticos usemos, más rápido se hace el proceso de la bacteria para desarrollar resistencia.
El resultado del mal uso y el uso excesivo, tanto en la salud humana como animal, es una carrera continua para mantenerse al frente de los supermicrobios.
Años de pruebas
Es fácil encontrar sustancias químicas que maten bacterias.
Es mucho más difícil descubrir y desarrollar sustancias que no sean también tóxicas para los humanos.
Fuente de la imagen, AFP
El camino hacia el descubrimiento de medicinas clínicamente aprobadas es necesariamente largo, y la tasa de fracasos es alta.
El proceso comienza con la investigación básica para identificar organismos que producen sustancias antibióticas.
Miles de posibilidades serán analizadas, lo cual es un proceso que puede tomar años.
Los científicos observan diferentes químicos, combinaciones de químicos y formas de debilitar a la bacteria.
Algunos intentarán atacar la pared celular, otros interferirán con la forma como la célula bacteriana funciona, o con su metabolismo.
Cuando se encuentra un candidato éste debe ser probado con bacterias infecciosas conocidas.
Después, si el resultado es prometedor, será analizado para ver su posibilidad de toxicidad en el humano y debe ser producido a escala.
Sólo entonces podrán comenzar los años de los ensayos clínicos.
En total toma entre 10 y 20 años desde el descubrimiento hasta el fármaco.
Sin nuevos descubrimientos
Por supuesto, con la complejidad y la incertidumbre surge el costo.
Y aquí es donde la crisis económica entra en juego.

Fuente de la imagen, Getty Images
Los antibióticos no sólo son complejos de desarrollar, los nuevos productos más innovadores no pueden ser vendidos con libertad.
Éstos deben colocarse en reserva para los casos más graves, como ocurre con la colistina, "el fármaco de último recurso".
Esto no presenta una oportunidad de inversión atractiva y durante los últimos 30 años las compañías farmacéuticas han reducido significativamente su trabajo para desarrollar nuevas terapias antibacterianas.
Durante décadas, ninguna clase nueva de antibióticos ha sido inventada.
De hecho, todos los antibióticos que llegaron al mercado en los últimos 30 años han sido variantes de los fármacos existentes descubiertos hasta 1984.
Lo más preocupante es que fue desde 1962 cuando se descubrieron las últimas nuevas generaciones de antibióticos para tratar a los infectados con las superbacterias gram-negativas más resistentes.

Fuente de la imagen, Getty Images
Estas incluyen las bacterias multirresistentes que pueden causar infecciones del flujo sanguíneo que son a menudo graves y letales y la neumonía.
Estas son una amenaza principalmente en hospitales, asilos y pacientes tratados con dispositivos como respiradores artificiales y catéteres.
Otras prioridades incluyen las bacterias resistentes a los medicamentos que pueden causar enfermedades más comunes como la gonorrea y la intoxicación alimentaria causada por salmonella.
En años recientes, a medida que se ha incrementado la concientización de las infecciones resistentes a los fármacos y los políticos han prestado atención a las advertencias de médicos y científicos, los sectores públicos y privados han comenzado a trabajar juntos para encontrar soluciones.
Para mayo de 2017, un total de 51 antibióticos estaban en proyecto clínico, casi una tercera parte dirigidos contra los principales patógenos: 12 familias de bacterias consideradas como las mayores amenazas a la salud humana.
Pero sólo un pequeño número son productos innovadores, los que no están basados en las clases existentes de antibióticos.
No sólo suerte
Los nuevos fármacos son vitales pero son sólo parte de la solución.
También necesitamos, en primer lugar, explorar el potencial de las vacunas para proteger contra las infecciones.

Fuente de la imagen, Getty Images
Y los diagnósticos mejores y más precisos de infecciones pueden ayudar a los médicos a saber rápidamente cuál es el mejor y más apropiado tratamiento.
También necesitamos un mejor entendimiento de dónde se están propagando las infecciones fármacorresistentes, no sólo en la gente sino en animales y el medio ambiente.
Mejorar la higiene en hospitales, clínicas y comunidades en todo el mundo podría ayudar a que la infección se propague en primer lugar.
Si queremos tener éxito en ganarle la carrera a los superbacterias no podemos confiar solamente en la suerte que tuvo Fleming en 1928.
Se necesita hacer más para asegurar que la industria y los gobiernos trabajan juntos para probar tratamientos prometedores y llevarlos al mercado.
Quizás lo más importante es que debemos darle a esta medicina milagrosa y maravillosa el respeto que se merece.
Los antibióticos, viejos y nuevos, son un recurso valioso que debe ser usado sólo cuando es necesario para proteger y mejorar la salud.
*Tim Jinks es jefe de infecciones fármacorresistentes de Wellcome Trust, una organización global independiente de investigación biomédica basada en Londres.











